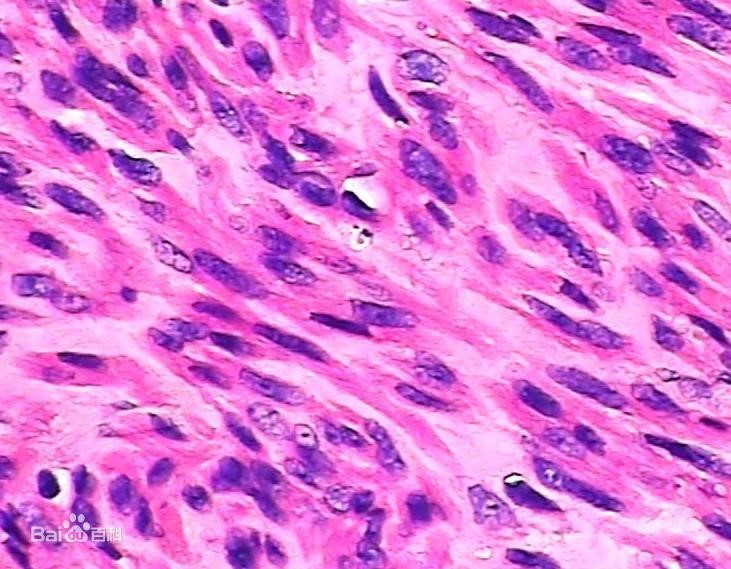
新闻图片2

14 年
手机商铺
公司新闻/正文
718 人阅读发布时间:2022-05-05 14:53
当疾病侵入人体,会引起相应病灶部位的病理性改变,对于相应病灶部位的观察经大量应用于临床工作及科学研究。20世纪90年代病理检查进入组化、免疫组化、分子生物学及癌基因检查。 随着自然科学的迅速发展,新仪器设备和技术应用到医学中来, 超微结构病理、分子病理学、免疫病理学、遗传病理学等方法也都应用到病理检查中。

癌细胞活体切片图
为探讨器官、组织或细胞所发生的疾病过程,可采用某种病理形态学检查的方法,检查他们所发生的病变 ,探讨病变产生的原因、发病机理、病变的发生发展过程,最后做出病理诊断。
今天我们要介绍的产品,就是在病理学以及疾病研究中常用的染色剂——苏木素-伊红(HE)染色试剂盒(abs9217)
hematoxylin — 伊红染色法 ( hematoxylin-eosin staining ) ,简称HE染色法 ,石蜡切片技术里常用的染色法之一 。hematoxylin染液为碱性 ,主要使细胞核内的染色质与胞质内的核酸着紫蓝色 ;伊红为酸性染料 ,主要使细胞质和细胞外基质中的成分着红色 。HE染色法是组织学、胚胎学、病理学教学与科研中最基本、使用最广泛的技术方法。
HE染色图
易于被碱性或酸性染料着色的性质称为嗜碱性( basophilia )和嗜酸性( acidophilia );而对碱性染料和酸性染料亲和力都比较弱的现象称为中性(neutrophilia)。
构成组织内蛋白质的氨基酸的种类很多,它们有不同的等电点。在普通染色法中,染色液的酸碱度为pH6左右,细胞内的酸性物质如细胞核的染色质、腺细胞和神经细胞内的粗面内质网及透明软骨基质等均被碱性染料染色,这些物质称为嗜碱性。而细胞质中的其它蛋白质如红细胞中的血红蛋白、嗜酸粒细胞的颗粒及胶原纤维和肌纤维等被酸性染料染色,这些物质称为嗜酸型。如果改变染色液的酸碱度,pH值升高时,则原来被酸性染料染色的物质可变为嗜碱性;pH值降低时,原来被碱性染料染色的物质则可变为嗜酸性。所以说染色液的pH值可以影响染色的反应。
脱氧核糖核酸(DNA)两条链上的磷酸基向外,带负电荷,呈酸性,很容易与带正电荷的hematoxylin碱性染料以离子键结合而被染色。hematoxylin在碱性溶液中呈蓝色,所以细胞核被染成蓝色。伊红Y是一种化学合成的酸性染料,在水中离解成带负电荷的阴离子,与蛋白质的氨基正电荷的阳离子结合使胞浆染色,细胞浆、红细胞、肌肉、结缔组织、嗜伊红颗粒等被染成不同程度的红色或粉红色,与蓝色的细胞核形成鲜明对比。伊红是细胞浆的良好染料。
由于组织或细胞的不同成分对hematoxylin的亲和力不同及染色性质不一样。经hematoxylin染色后,细胞核及钙盐粘液等呈蓝色,可用盐酸酒精分化和弱碱性溶液显蓝,如处理适宜,可使细胞核着清楚的深蓝色,胞浆等其它成分脱色。再利用胞浆染料伊红染胞浆,使胞浆的各种不同成分又呈现出深浅不同的粉红色。故各种组织或细胞成分与病变的一般形态结构特点均可显示出来。
爱必信生物为您提供高品质苏木素-伊红(HE)染色试剂盒(abs9217),其中包含经优化过的染液,可以令染色更清晰,背景更干净。
Absin特色产品线:
WB相关:ECL发光液、预染marker、预制胶;IHC相关:二抗试剂盒、组化笔;IP/CoIP试剂盒;激动剂/抑制剂;血清、BSA、蛋白酶K、CTB、TTX、CEE;凋亡试剂盒;呼吸爆发试剂盒;ELISA试剂盒;重组蛋白;抗体: 二抗、标签抗体、对照抗体;定制服务(抗体/多肽/蛋白/标记/检测)...
|
爱必信(上海)生物科技有限公司 联系邮箱:info@absin.cn 公众平台:爱必信生物 |